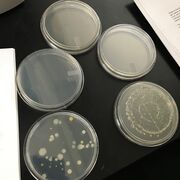

Uploads by Max Leopold
From OpenWetWare
Jump to navigationJump to search
This special page shows all uploaded files.
| Date | Name | Thumbnail | Size | Description |
|---|---|---|---|---|
| 18:23, 17 March 2016 | Food Web for Transect 1.jpg (file) |  |
77 KB | |
| 20:19, 18 February 2016 | IMG 3459.JPG (file) |  |
2.61 MB | |
| 20:18, 18 February 2016 | Fungiblackbreadmold.JPG (file) |  |
1.69 MB | |
| 20:15, 18 February 2016 | Plant 1 Feburary 18.JPG (file) |  |
1.83 MB | |
| 21:12, 11 February 2016 | IMG 3440.JPG (file) | |
1.4 MB | |
| 16:07, 2 February 2016 | 3342.JPG (file) |  |
936 KB | |
| 15:57, 2 February 2016 | IMG 3342.JPG (file) |  |
936 KB |